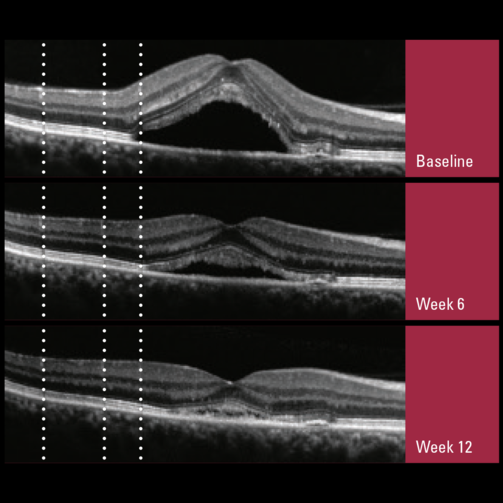
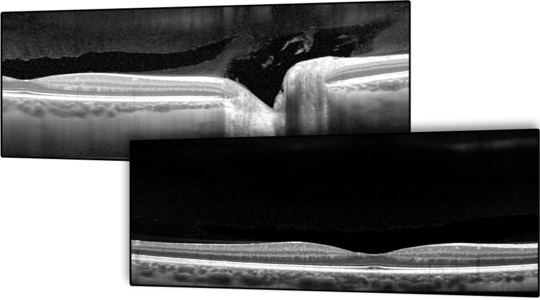
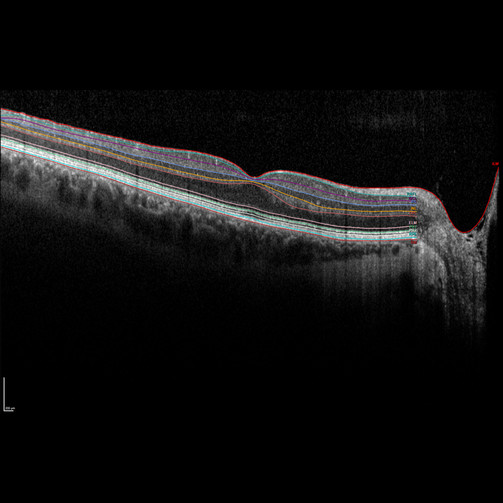

Parceiro Exclusivo no Brasil


Plataforma de imagem multimodal otimizada para o segmento posterior. O SPECTRALIS uma plataforma de imagem oftalmológica com design modular e atualizável.
Esta plataforma permite que os médicos configurem cada SPECTRALIS para o fluxo de trabalho de diagnóstico específico do consultório ou clínica.

As opções de imagem multimodal fazem do spectralis uma plataforma exclusiva para imagens de alta resolução e definição, com velocidade variável 20,85 e 125 Khz, Óptica confocal, TruTrack Active Eye Tracking ™, redução de ruído (desvio padrão de 1 micra), visualização das 10 camadas da retina, módulos Glaucoma Module Premium Edition, Multicolor, OCTA, Nsite, Campo Amplo 55 em OCT ou 102 graus para Angiografia e ICG.
Entregam um acompanhamento seguro de todas as patologias da retina e uma prática personalizada.

Spectralis
Plataforma de Imagem Multimodal Otimizada para o Segmento Posterior
O SPECTRALIS® é uma plataforma de imagem oftálmica com design modular e atualizável. Essa plataforma permite que os clínicos configurem cada SPECTRALIS de acordo com o fluxo de trabalho diagnóstico específico da prática ou clínica.
As opções de imagem multimodal incluem: OCT, múltiplas modalidades de imagem de fundo com laser de varredura, imagens de campo amplo e ultra-amplo, angiografia com laser de varredura e angiografia OCT.
O DNA do Spectralis :
A alta definição e a alta resolução são parte do DNA do Spectralis
- É uma tecnologia para tomografia ocular Spectral Domain (SD-OCT)
Plataforma Atualizável
O SPECTRALIS® é uma plataforma de imagem verdadeiramente flexível e atualizável. Personalize seu SPECTRALIS de acordo com suas necessidades individuais, com a confiança de que seu OCT evoluirá juntamente com sua clínica. À medida que novas tecnologias se tornam disponíveis, basta adicionar novas modalidades de imagem ao seu SPECTRALIS, fornecendo informações adicionais para aprimorar a tomada de decisões clínicas e preservando os dados do paciente para um acompanhamento preciso.

Oftalmoscopia a Laser de Varredura Confocal
O oftalmoscópio a laser de varredura confocal (cSLO) na plataforma SPECTRALIS® é uma tecnologia inovadora para examinar e obter imagens da retina e de outras estruturas oculares.
Combinando a seletividade da luz laser com a resolução precisa da varredura confocal, o cSLO oferece detalhes e clareza de imagem que não estão disponíveis na fotografia de fundo de olho.
A tecnologia cSLO não apenas oferece documentação dos achados clínicos, mas também frequentemente destaca detalhes diagnósticos críticos que não são visíveis na oftalmoscopia clínica tradicional. Como a imagem cSLO minimiza os efeitos da dispersão da luz, pode ser utilizada de forma eficaz mesmo em pacientes com catarata.

Diagnóstico Multimodal
A combinação única de modalidades de imagem fornece as informações adicionais necessárias para tomar decisões clínicas confiantes. Utilize diferentes técnicas de imagem, tanto estabelecidas quanto novas, simultaneamente, para aprimorar sua compreensão de diversas patologias.

TruTrack Active Eye Tracking
O TruTrack Active Eye Tracking é uma tecnologia de imagem patenteada que utiliza dois feixes de luz simultaneamente para rastrear e capturar imagens do olho. Ao rastrear ativamente o olho em tempo real durante a captura de imagens, o sistema mitiga os efeitos do movimento ocular, resultando em dados de varredura OCT precisos.
Os benefícios clínicos adicionais do TruTrack Active Eye Tracking incluem rastreamento automatizado preciso para acompanhamento da retina, reprodutibilidade na medição da espessura retinal de até 1 mícron e excelente qualidade de imagem ao longo de toda a varredura do volume. Esse desempenho superior permite um manejo mais eficaz dos pacientes, mesmo em casos desafiadores com alterações muito pequenas ao longo do tempo.

AutoRescan
Utilizando a imagem de fundo do SPECTRALIS® como um mapa, a função AutoRescan posiciona automaticamente as varreduras de acompanhamento no local exato a cada visita. O posicionamento preciso e automático das varreduras de acompanhamento é importante para otimizar o fluxo de pacientes e para o reconhecimento confiável das pequenas mudanças estruturais, que são essenciais para o manejo eficaz de várias condições oftálmicas.
Estudos demonstraram que o SPECTRALIS com a tecnologia AutoRescan pode medir de forma confiável alterações na espessura da retina tão pequenas quanto 1 mícra.
Redução de Ruído
A Redução de Ruído SPECTRALIS® é uma tecnologia proprietária que remove o ruído presente nas imagens de OCT e laser de varredura. Ao capturar várias imagens no exato mesmo local, essa tecnologia é capaz de diferenciar as informações estruturais do ruído e, em seguida, removê-lo de forma eficaz.
As imagens resultantes, desde o vítreo até a coróide e por todo o polo posterior, possuem alto contraste e detalhes excepcionais. A tecnologia de Redução de Ruído SPECTRALIS é alimentada pelo TruTrack Active Eye Tracking, que permite a captura precisa de várias imagens no mesmo ponto anatômico – o elemento crítico para uma redução de ruído eficaz.

Visualização de 10 Camadas
O SPECTRALIS® oferece imagens OCT de alta resolução para visualização de 10 camadas da retina, ajudando você a descrever e identificar com confiança as patologias.

* Os Módulos do Spectralis:
1.Modulo:Shift
Tecnologia SHIFT
A SHIFT é uma tecnologia exclusiva do SPECTRALIS® que permite alternar entre diferentes velocidades de varredura OCT, encontrando o equilíbrio ideal entre qualidade e fluxo de trabalho, tanto para o operador quanto para o clínico, a fim de proporcionar um atendimento personalizado ao paciente. A SHIFT, combinada com outras tecnologias essenciais do SPECTRALIS, otimiza o desempenho ao oferecer diferentes velocidades de varredura para alcançar melhores resultados em termos de velocidade, qualidade da imagem, nitidez e detalhes em diversas aplicações.
As configurações padrão garantem um fluxo de trabalho eficiente, enquanto ainda há flexibilidade para ajustar a velocidade de varredura, se necessário.

Velocidade de Varredura de 20 kHz
Às vezes, mais devagar é melhor.
A velocidade de varredura de 20 kHz permite a obtenção de imagens clinicamente significativas, mesmo nos casos mais desafiadores. Devido à exposição prolongada à luz e ao melhor índice de sinal-ruído, o SPECTRALIS® oferece suporte ao fornecer imagens utilizáveis, mesmo em olhos com opacidades.
Em casos de catarata, edema corneal ou flutuantes densos, a tecnologia SHIFT ajuda a alcançar uma qualidade de imagem excepcional, proporcionando uma visão diagnóstica das estruturas do segmento posterior, onde outros dispositivos ou velocidades de varredura padrão não conseguem oferecer qualidade suficiente para proporcionar um atendimento personalizado aos pacientes.

Velocidade de Varredura de 85 kHz
A velocidade de varredura de 85 kHz permite a captura de imagens com alta resolução e rapidez, ideal para exames em larga escala e quando é necessário um fluxo de trabalho eficiente. Essa velocidade de varredura otimiza o tempo de exame, ao mesmo tempo em que mantém uma excelente qualidade de imagem, facilitando a análise precisa das estruturas oculares.
Velocidade de Varredura de 125 kHz
Às vezes, mais rápido é melhor.
A velocidade de varredura de 125 kHz oferece imagens ainda mais rápidas, mantendo alta qualidade e precisão. Ideal para exames em tempo reduzido, essa velocidade é especialmente útil quando é necessário capturar uma grande quantidade de imagens de forma eficiente, sem comprometer a clareza e o detalhe, proporcionando um fluxo de trabalho mais ágil.

2.Módulo de Glaucoma Edição Premium (GMPE)
Diagnóstico de glaucom a de próxima geração
A Edição Premium do Módulo de Glaucoma SPECTRALIS® combina o exclusivo Sistema de Posicionamento Anatômico (APS) com uma série de padrões de varredura únicos para avaliar o disco óptico, a camada de fibras nervosas da retina e a camada de células ganglionares da mácula. Esses padrões de varredura baseados no APS são automaticamente ajustados aos marcos anatômicos exclusivos de cada olho e às características das finas estruturas anatômicas relevantes para o diagnóstico de glaucoma.
A Edição Premium do Módulo de Glaucoma compara os olhos dos pacientes a um banco de dados de referência de olhos normais, detectando até mesmo as pequenas variações. A precisão da função AutoRescan do SPECTRALIS permite a identificação e o monitoramento confiável de alterações estruturais ao longo das visitas, proporcionando um acompanhamento contínuo e preciso da progressão do glaucoma.

- Sistema de Posicionamento Anatômico (APS)
Combina o exclusivo Sistema de Posicionamento Anatômico (APS) com uma série de padrões de varredura únicos para avaliar o disco óptico, a camada de fibras nervosas da retina e a camada de células ganglionares da mácula. Esses padrões de varredura baseados no APS são automaticamente ajustados aos marcos anatômicos exclusivos de cada olho e às características das finas estruturas anatômicas relevantes para o diagnóstico de glaucoma.
A Edição Premium do Módulo de Glaucoma compara os olhos dos pacientes a um banco de dados de referência de olhos normais, detectando até mesmo as pequenas variações. A precisão da função AutoRescan do SPECTRALIS permite a identificação e o monitoramento confiável de alterações estruturais de uma visita para a outra.

- Cabeça do nervo Óptico

- Camada de Fibras Nervosas da Retina (RNFL)

- Polo Posterior
- Relatório de Glaucoma de Hood

- Mapas de Desvio
O poder de discriminação dos mapas de desvio permite visualizar a perda estrutural de forma rápida e clara. A comparação das medições de espessura com o banco de dados de referência (RDB) aumenta o valor diagnóstico dos mapas de espessura. Os mapas de desvio resultantes destacam a probabilidade de medições de espessura que não estão “Dentro dos Limites Normais”, revelando regiões e padrões associados dentro de camadas retinianas específicas que apresentam valores estatisticamente significativos mais finos ou mais espessos.



-
Endereço
Av. Professor João Fiúsa, 1.901
Salas 901 e 902 – 14024-250
Jardim Canadá, Ribeirão Preto, SP -
Horário de Atendimento
De segunda a sexta-feira (exceto feriado)
Das 8h às 18h